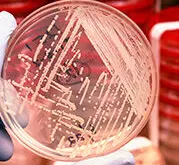

Symptoms and Types of Tuberculosis
Tuberculosis (TB) is caused by Mycobacterium tuberculosis and related mycobacterial species. The infection can affect different parts of the body, leading to a variety of clinical forms. Understanding the main symptoms and classifications of TB is essential for research and scientific communication.
Common Symptoms of Active TB
- Persistent Cough: Usually lasting longer than three weeks.
- Chest Pain and Breathing Difficulties: Caused by lung tissue damage or pleural involvement.
- Weight Loss: A frequent consequence of prolonged infection.
- Night Sweats: Characteristic symptom linked to systemic infection.
- Fever and Fatigue: General signs of ongoing bacterial activity.

=>>These symptoms are associated mainly with pulmonary TB, but can also occur in extra-pulmonary forms depending on the affected organ.
Types of Tuberculosis
Dedicated professionals driving our success

1.Pulmonary Tuberculosis
- The most common form.
- Affects the lungs and is the main source of transmission.
- Characterized by cough, chest pain, and hemoptysis (coughing up blood).

2.Extra-Pulmonary Tuberculosis
Occurs when bacteria spread outside the lungs. Important subtypes include:
- Lymphatic TB: Involves lymph nodes, especially in the neck region.
- Skeletal TB: Affects bones and joints, often the spine (Pott’s disease).
- Genitourinary TB: Involves kidneys, bladder, or reproductive organs.
- Meningeal TB: Infection of the meninges surrounding the brain and spinal cord.
- Abdominal TB: Targets gastrointestinal tract, peritoneum, or associated organs.

3.Latent Tuberculosis
- The bacteria remain in the body without causing symptoms.
- Not contagious but represents a potential reservoir for reactivation.
4.Antibiotic Resistance in Tuberculosis (Research Context)
- Certain Mycobacterium tuberculosis strains have developed resistance to commonly used antibiotics.
- These resistant forms are studied and classified in research under different categories (e.g., MDR-TB and XDR-TB).
- This topic represents an important area of investigation, as it provides insights into bacterial adaptation and global health challenges.
Educational Video: Learn About Tuberculosis
Tuberculosis: Causes, Symptoms, Diagnosis & Treatment
Tuberculosis or TB is a contagious infection that normally affects the lungs. It can also spread to other parts of the body, like spine, kidneys and brain. A type of bacterium called Mycobacterium tuberculosis causes it.
There are two types of Tuberculosis: Latent TB and Active TB.
Common signs of active TB include:
- A cough that lasts more than 3 weeks and coughing up blood.
- Chest pain and constant tiredness.
- Fever, chills, and night sweats.
- Loss of appetite and weight loss.
=> The video explains TB in a simple way, making it suitable for educational purposes.